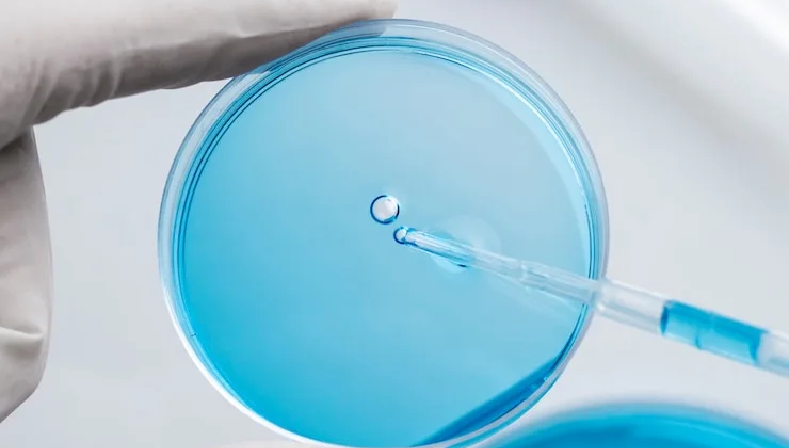

Home > Treatments > Female Infertility >
In Vitro Maturation (IVM)
At Mamata Fertility Hospital in Secunderabad, we are dedicated to providing world-class fertility treatments designed to meet the unique needs of every patient. One of the pioneering techniques available at our facility is In Vitro Maturation (IVM)—an innovative solution for women who may not be ideal candidates for conventional IVF. This advanced fertility treatment provides a safer and gentler approach to achieving parenthood while maintaining excellent success rates.
Our team of highly skilled fertility specialists, state-of-the-art technology, and compassionate care make Mamata Fertility Hospital your trusted partner on the road to parenthood.
QUICK FACTS
- Hospital stay: Approx 1 day
- Anaesthesia: Local
- Covered by health insurance? Yes
- Procedure duration: ~20 minutes.
98% of our patients are likely to recommend us to their peers
Transparent & Empathetic Process
Comprehensive & Prompt Care
Internationally & nationally renowned consultants
For Appointment, Please Call:
What is In Vitro Maturation?
In Vitro Maturation (IVM) is a revolutionary fertility treatment where immature eggs are retrieved from the ovaries and matured in a laboratory setting. This is different from conventional IVF, where mature eggs are collected after the use of stimulating medications to promote egg growth.
IVM is particularly helpful for patients who are sensitive to hormonal stimulation or want to avoid the risks associated with high-dose fertility medications, such as ovarian hyperstimulation syndrome (OHSS).
The eggs are collected at an earlier stage and then carefully cultured in a lab using advanced techniques. Once the eggs reach full maturation, they are fertilized with sperm through intracytoplasmic sperm injection (ICSI) and the resulting embryos are transferred into the uterus.
Key Differences Between IVM and IVF:
- IVM: Immature eggs are collected and matured in the lab.
- IVF: Mature eggs are collected after ovarian stimulation.
IVM is one of the advanced fertility treatments that balances safety, cost, and effectiveness, and it has become a viable alternative for many individuals facing fertility challenges.
Benefits of IVM
Our expertise in providing IVM in Secunderabad allows patients to benefit from this advanced technique, particularly in situations where conventional IVF may not be ideal. Here are the key benefits of IVM:
1. Reduced Medication
IVM significantly reduces the use of fertility drugs, minimizing potential side effects and costs associated with medication.
2. Lower Risk of OHSS
Patients at risk of ovarian hyperstimulation syndrome (OHSS)—a condition associated with high hormone levels during conventional IVF—can safely undergo IVM with minimal risk.
3. Cost-Effective
Since fewer medications are needed in IVM cycles, it is often more affordable than conventional IVF.
4. Suitable for PCOS Patients
Women with polycystic ovary syndrome (PCOS), who are particularly vulnerable to OHSS, can benefit from the gentler approach of IVM.
5. Faster Treatment
IVM eliminates the prolonged ovarian stimulation phase of traditional IVF, reducing the overall treatment time.
6. Safer for Young Cancer Patients
For women needing fertility preservation before cancer treatment, IVM avoids the high hormone levels that could exacerbate hormone-sensitive cancers.
At Mamata Fertility Hospital, we maximize these benefits to make IVM accessible and effective for a broad range of patients seeking to grow their families.
Who Can Benefit from IVM?
IVM is an ideal fertility treatment for specific groups of individuals. Our specialists at Mamata Fertility Hospital in Secunderabad carefully assess each patient’s medical history and fertility challenges to determine if IVM is a suitable option. Below are some of the candidates for IVM:
1. Women with PCOS
Polycystic ovary syndrome often causes an excess of small, immature eggs. IVM allows these eggs to mature in the lab without requiring heavier stimulation.
2. Patients at Risk of OHSS
IVM is tailored for women who are prone to ovarian hyperstimulation, offering a safer alternative to conventional IVF.
3. Women with Poor Ovarian Response
For individuals who produce limited mature eggs with conventional ovarian stimulation, IVM can be an effective solution.
4. Cancer Patients Seeking Fertility Preservation
Young women diagnosed with cancer can benefit from IVM by quickly retrieving and maturing eggs before undergoing chemotherapy or radiation therapy.
5. Women Preferring Minimal Hormonal Interventions
For patients who want to avoid large hormone doses during fertility treatments, IVM is a gentler and less invasive choice.
At Mamata Fertility Hospital, we ensure that every treatment plan, including IVM, is uniquely personalized to the specific needs of each patient.
The Procedure
The IVM procedure is seamless and well-coordinated at Mamata Fertility Hospital, giving patients a stress-free experience. Here’s a step-by-step explanation of what the process involves:
Step 1. Consultation and Assessments
- Patients meet with our fertility experts to discuss their medical history, undergo fertility evaluations, and determine if IVM is the right approach.
Step 2. Minimal Ovarian Stimulation
- Patients receive minimal or no hormonal stimulation, avoiding the intense medication schedules associated with conventional IVF.
Step 3. Egg Retrieval
- Immature eggs are collected from the ovaries using a gentle aspiration technique performed under ultrasound guidance.
Step 4. Egg Maturation in the Lab
- The collected immature eggs are carefully cultured in a specialized laboratory environment to support full maturation.
Step 5. Fertilization
- Once the eggs have matured, they are fertilized using ICSI, where a single sperm is injected into each egg.
Step 6. Embryo Development
- The fertilized eggs are monitored as they develop into embryos, which are evaluated for quality and readiness for transfer.
Step 7. Embryo Transfer
- The best-quality embryos are transferred to the uterus in a safe and precise manner.
Step 8. Pregnancy Test
- About 10–14 days after the transfer, a pregnancy test is conducted to confirm implantation.
Throughout the process, our team at Mamata Fertility Hospital ensures that patients receive close monitoring, guidance, and care.
IVM vs IVF vs ICSI
When exploring fertility treatment options, it’s important to understand the differences between IVM, IVF, and ICSI. Each technique is designed to address specific fertility challenges, and the choice depends on individual circumstances. Below is a detailed comparison to help clarify these options:
|
Aspect |
IVM |
IVF |
ICSI |
|
Procedure |
Eggs are retrieved immature and matured in the lab. |
Mature eggs are retrieved after ovarian stimulation. |
Similar to IVF, but involves injecting a single sperm into the egg. |
|
Medications Used |
Minimal or no hormonal stimulation. |
Requires weeks of ovarian stimulation using fertility drugs. |
Same as IVF (uses hormones for egg development). |
|
Ideal Candidates |
Women with PCOS, OHSS risk, or hormonal sensitivity. |
Couples with general infertility or poor ovarian reserve. |
Couples with male-factor infertility (low sperm count or motility). |
|
Benefits |
Fewer medications, lower costs, faster process. |
High success rates, ability to freeze surplus embryos. |
Effective for severe male infertility. |
|
Risks |
Slightly lower success rates compared to IVF; immature egg recovery may be variable. |
Risk of OHSS or side effects from medications. |
Requires advanced lab techniques. |
|
Treatment Goal |
Minimizing risks while achieving similar success as IVF. |
Producing multiple eggs and embryos for transfer. |
Ensures fertilization for couples with significant sperm issues. |
Each of these fertility procedures is highly advanced and effective in its own way, but choosing the right one depends on the specific fertility challenges faced by a couple. At Mamata Fertility Hospital in Secunderabad, our specialists ensure careful evaluation and personalized recommendations, allowing couples to pursue the most suitable treatment.
Making the Right Decision
Choosing between IVM, IVF, or ICSI can feel overwhelming, but at Mamata Fertility Hospital, we are here to guide you every step of the way. The choice of treatment depends on a combination of medical history, fertility diagnosis, and individual preferences. Here’s how you can make an informed decision:
1. Understand Your Fertility Needs
Each couple’s fertility challenges are unique, and a one-size-fits-all solution does not exist. For instance:
- If you have PCOS or are sensitive to hormone stimulation, IVM may be the best fit.
- If the male partner has infertility issues like low sperm count or motility, ICSI might be more suitable.
- For unexplained infertility or if you prefer a tried-and-tested option, IVF could be ideal.
2. Consult with Experts
At Mamata Fertility Hospital, we prioritize patient education and personalized care. During your consultation:
- Our specialists will review your medical reports and conduct advanced diagnostic tests.
- You’ll receive tailored advice on which fertility treatment aligns with your health condition and family-building goals.
3. Consider Broader Factors
Your age, overall health, financial situation, and emotional readiness all play a role in choosing the right approach. For example:
- If time is a concern, IVM may appeal because of shorter treatment durations.
- For couples considering fertility preservation or future family planning, IVF may offer the benefits of embryo freezing.
4. Look for Transparent Communication and Support
Selecting the right fertility treatment goes beyond medical factors—it’s about feeling confident and cared for throughout your journey. That’s why Mamata Fertility Hospital emphasizes clear communication, patient support, and transparency about treatment success rates and costs.
At the end of the day, your fertility care plan should reflect what feels right for you. No matter which procedure you choose, rest assured that Mamata Fertility Hospital brings unparalleled expertise and state-of-the-art technologies to ensure the highest chances of success.
Contact us today to book a consultation and take the first step toward selecting the fertility treatment that’s right for you! Our compassionate team of specialists at Mamata Fertility Hospital in Secunderabad is ready to guide you toward fulfilling your dream of parenthood.
Success Rates
IVM has shown significant success in addressing fertility challenges, particularly in patients with PCOS or those at risk of OHSS. At Mamata Fertility Hospital in Secunderabad, we use advanced techniques to ensure optimal outcomes for our patients.
IVM Success Factors:
- Patient Age
Younger women often achieve higher success rates with IVM due to better-quality eggs. - Egg and Sperm Quality
The developmental potential of the retrieved eggs and sperm greatly influences the success of IVM cycles. - Laboratory Expertise
Our state-of-the-art lab and experienced embryologists promote optimal conditions for egg maturation and embryo development.
The success rates of IVM are generally comparable to conventional IVF when performed for appropriate candidates, especially in our specialized fertility center.
Cost of IVM in Secunderabad
The cost of IVM differs based on individual circumstances. At Mamata Fertility Hospital, we believe in providing transparent pricing and flexible payment options to support our patients.
Breakdown of Costs:
- The cost of IVM treatment typically ranges between ₹1,50,000–₹2,50,000, depending on the level of care required.
- This is relatively economical compared to traditional IVF cycles since it reduces the cost of medications significantly.
Our financial counselors are available to help patients understand the costs and explore payment plans that align with their needs and budget.
FAQs
1. What is the difference between IVM and IVF?
IVM involves retrieving immature eggs and maturing them in the lab, while IVF retrieves mature eggs after ovarian stimulation. IVM uses fewer medications and is less invasive.
2. Is IVM safe?
Yes, IVM is a safe and effective procedure, especially for patients who cannot undergo conventional IVF due to risks like OHSS.
3. How successful is IVM?
The success rates of IVM are comparable to IVF for appropriate candidates, particularly when performed in a specialized fertility center like Mamata Fertility Hospital.
4. Who is a candidate for IVM?
IVM is ideal for women with PCOS, those at risk of OHSS, or individuals preferring minimal hormonal stimulation.
5. Is IVM less expensive than IVF?
Yes, IVM is generally more affordable since it requires fewer medications and shorter treatment cycles.
6. Can IVM be used for fertility preservation?
Yes, IVM is an excellent option for fertility preservation, particularly for women diagnosed with cancer who need quick hormonal-free egg retrieval.
We Can Help You With All The Possible Infertility Treatments.
WHAT PATIENTS EXPERIENCE AT MAMATA FERTILITY?
“I had an excellent first visit to Mamata Hospitals, where I met Dr. Mamata madam and Dr. Arti. Madam and Dr cheatn The process was systematic, instilling confidence that my issues will be effectively addressed. The staff and doctors were incredibly friendly and supportive, making me feel at ease. Their professionalism and warmth have given me great confidence in their care. I look forward to sharing more about my journey in detail.”
Vishu S.N
At Mamata Fertility Hospital in Secunderabad, we are proud to offer In Vitro Maturation (IVM) as a part of our comprehensive fertility care services. This groundbreaking technique underscores our dedication to using innovative, patient-centric approaches to help couples achieve their dreams of parenthood.
Contact us today to schedule your consultation and take the first step toward successful fertility treatment with confidence!

Dr Aarti Deenadayal Tolani
MBBS, MS ( OBGYN), FICOG
Clinical Director, Scientific In- Charge & Fertility Consultant with 15+ years Of Experience

